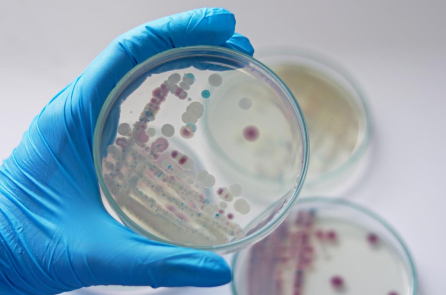
Mỹ: Massachusetts đưa ra cảnh báo về ‘vi khuẩn ăn thịt người’ Vibrio vulnificus

Mối nguy hại từ kim loại nặng trong các thực phẩm hàng ngày
Trong căn bếp của mỗi gia đình, những thực phẩm quen thuộc như bánh mì, gạo hay hải sản vẫn được xem là nguồn dưỡng chất an toàn. Thế nhưng ẩn trong đó lại có…

FDA đình chỉ việc cấp phép vắc-xin Chikungunya
Ngày 25/8, Cục Quản lý Thực phẩm và Dược phẩm Hoa Kỳ (FDA) thông báo đình chỉ việc chấp thuận vắc-xin Ixchiq phòng bệnh Chikungunya do công ty Valneva (Pháp) sản xuất. Ixchiq là loại…

8 lợi ích sức khỏe khi ăn quả chà là
Những quả chà là đẹp mắt không chỉ cung cấp nhiều dưỡng chất, giúp kháng viêm, ngăn ngừa khối u, tốt cho xương khớp, mà còn là vị thuốc nổi tiếng có tác dụng dưỡng…

Vì sao ngày càng nhiều thanh thiếu niên tự ái, thích đề cao bản thân?
Nhiều chuyên gia cho biết, ảnh hưởng của mạng xã hội, hiện tượng nâng điểm ở trường học cùng các yếu tố môi trường khác đã dẫn đến chứng ái kỷ (narcissism) đang ngày càng…

Nguy cơ nhiễm “amip ăn não” khi bơi lội, vui chơi dưới sông hồ vào mùa hè
Theo tờ Fox News đưa tin, một người trưởng thành ở tiểu bang Missouri (Hoa Kỳ) vừa được chẩn đoán nhiễm viêm não – màng não nguyên phát do amip ăn não Naegleria fowleri, sau…

Uống rượu mỗi ngày suốt 5 năm, người đàn ông phải nhập viện cấp cứu
Nam bệnh nhân 47 tuổi nhập viện trong tình trạng đau bụng dữ dội vùng thượng vị, buồn nôn, bụng chướng nhiều.

Nguy cơ suy tim đang gia tăng ở người trẻ
Ít vận động và thói quen sinh hoạt kém lành mạnh có thể gây tổn hại cho chức năng tim, kéo theo hệ lụy suy tim ở người trẻ đang ngày càng tăng lên. Mới…

Tại sao ăn đúng cách hiệu quả hơn ăn kiêng?
Nhiều người cố gắng ăn kiêng để giảm cân, nhưng cuối cùng lại không thể duy trì kết quả. Chuyên gia về béo phì – ông Cai Mingjie – chia sẻ trong 1 chương trình…

Ung thư không chỉ là vấn đề về khí huyết, Trung y xác định 4 căn nguyên
Khí huyết là biểu hiện của chức năng sinh lý cơ thể.

Lời khuyên của ChatGPT khiến một người đàn ông nhập viện vì ngộ độc hóa chất nguy hiểm
Một người đàn ông đã bị ngộ độc hóa chất nguy hiểm và phải nhập viện sau khi sử dụng ChatGPT để được tư vấn về liệu pháp ăn uống. Dùng AI làm suy giảm…

Tăng nguy cơ gãy xương khi dùng liệu pháp hormon thay thế?
Một nghiên cứu mới đăng trên tạp chí y khoa nổi tiếng The Lancet, đã mang đến những kết quả đầy bất ngờ có thể giúp phụ nữ cân nhắc kỹ lưỡng hơn về thời…

Ngũ hành và những dấu hiệu sớm của bệnh tật
Điều gì làm nên một người thầy thuốc giỏi nhất? Là khả năng chữa trị bệnh nan y, hay là cứu sống bệnh nhân khi đã cận kề cái chết? Theo quan niệm Trung y,…

CDC Hoa Kỳ bị kiện vì lịch tiêm vắc-xin cho trẻ em
Trung tâm Kiểm soát và Phòng ngừa Dịch bệnh (CDC) Hoa Kỳ bị kiện vì đã không tiến hành kiểm nghiệm đầy đủ đối với lịch tiêm vắc-xin cho trẻ em.

Một số loại thuốc và thực phẩm chức năng quen thuộc có thể gây hại cho gan
Các chuyên gia cảnh báo về những nguy cơ ẩn giấu từ những loại thuốc và thực phẩm chức năng thông dụng khi số ca tổn thương gan do độc tố ngày càng nhiều. Dưỡng…

2 loại thuốc nhuộm tóc tự nhiên giúp nuôi dưỡng da đầu, giảm nguy cơ ung thư
Nếu bạn muốn lưu giữ vẻ ngoài tươi trẻ, rạng rỡ bằng cách nhuộm tóc thường xuyên, hãy thử cân nhắc lại. Các loại hóa chất tiềm ẩn trong thuốc nhuộm tóc thông thường –…

Các thuốc giảm cân phổ biến có thể liên quan đến nguy cơ mất thị lực đột ngột
Nghiên cứu mới đây cho thấy một số loại thuốc giảm cân có thể làm tăng nguy cơ mắc các bệnh lý nghiêm trọng về mắt, thậm chí có thể dẫn đến mất thị lực.…
Mỹ: Massachusetts đưa ra cảnh báo về ‘vi khuẩn ăn thịt người’ Vibrio vulnificus
Massachusetts cảnh báo về một loại vi khuẩn “ăn thịt người” có khả năng gây chết người xuất hiện ở vùng biển ven bờ của tiểu bang này sau khi một người bị nhiễm bệnh.

Nghiên cứu: Người tiêm vắc-xin COVID-19 dễ mắc bệnh đường hô hấp hơn
Nghiên cứu mới được công bố trên Nature Communications Medicine cho thấy những người đã tiêm ít nhất một liều vắc-xin COVID-19 có nguy cơ gặp phải các bệnh về hô hấp cao hơn. Cụ…

Ung thư đại trực tràng: 4 dấu hiệu không thể bỏ qua và phòng ngừa nhờ vận động
Ung thư đại trực tràng (UTĐTT) hiện là một trong những nguyên nhân tử vong hàng đầu do ung thư. Trong khi tỷ lệ mắc ở người lớn tuổi giảm nhờ tầm soát, thì ba…

Protein và 5 lợi ích cho sức khỏe não bộ
Lâu nay, nhắc đến protein, mọi người thường nghĩ đây là “vật liệu” giúp xây dựng khối cơ. Nhưng không chỉ dừng lại ở đó, protein còn đóng vai trò quan trọng trong việc duy…




















